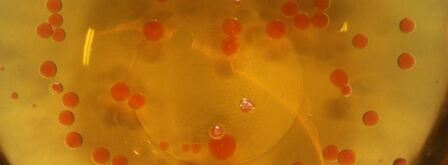
мусс из куриной печенки с икрой из морса. Шаг 6

Мусс из куриной печенки с икрой из морса
Рецепт от: Мина Лобкова
- Рецепт: Простой
- Время приготовления: 30 мин
- Порций: 1
- Калорий: 561 ккал
- Кухня: Авторская
Ингредиенты на
- печёнка куриная — 100 г
- лук репчатый — 2 шт.
- морковь — 1 шт.
- сливки — 100 мл
- коньяк — 20 мл
- масло оливковое — 300 мл
- масло сливочное — 10 г
- чеснок — 2 зубчик
- соль
- черный перец
- агар-агар — 5 г
- морс — 50 мл
Как приготовить
-
Заранее ставим в холодильник оливковое масло. Разогреваем сотейник с добавлением оливкового масла. Выкладываем морковь и лук. Обжариваем до золотистого цвета. Добавляем измельченные зубчики чеснока. Вливаем коньяк. Фламбируем.
-
2. Добавляем куриную печень. Обжариваем в течение трех минут. Все время помешиваем. Посолим и поперчим.

-
3. Вливаем сливки в печенку. Доводим до консистенции сметаны. Посолим. Измельчаем блендером.

-
4. Готовим икру. Вливаем в отдельный сотейник морс. Добавляем агар-агар. Перемешиваем. Нагреваем.

-
5. Наливаем в миску охлажденное оливковое масло. Как только начнет закипать морс, снимаем с огня. Кладем куриный мусс в банку. Украшаем базиликом.

-
6. Добавляем еще немного агар-агара в морс. Набираем морс в шприц. Капаем в охлажденное масло.

-
7. Откидываем икру через сито. Выкладываем на куриный мусс. Приятного аппетита!


Фото мусса иза куриной печенок с икроя иза морсы.

Клюквенный мусс
Мусс
Ежевичный мусс
Мусс
Обсуждение
Вкуснятина неописуемая!!!
С первого раза все сделала просто идеально!
Огромное спасибо за рецепт:)
Делаю мусс из куриной печенки с икрой из морса уже второй раз, просто бесподобно!
Спасибо Мина громадное за рецепт, а главное, за простоту и наглядность.
Вопросов не возникает.
Вот ещё нашла снежный мусс.
Обязательно приготовлю! :D:D:D
Спасибо за рецептик!
Мина, умничка!
Какой аппетитный рецептик мусса из куриной печенки с икрой из морса сварганила.
Попробуем с большим удовольствием!
Очень вкусно, сделала на Новый год, и буду теперь на каждый праздник делать, просто, украшение стола!
Именно мусс из куриной печенки с икрой из морса часто готовлю! И Рецепт практически как у меня. Приятно видеть, что многим это блюдо нравится.
Очень давно приметила этот рецептик мусса из куриной печенки с икрой из морса.
Получилось просто чудесно!
Мина спасибо Вам большое за этот рецепт!
Мина, ОГРОМНОЕ спасибо за Ваш рецепт, за иллюстрации!!!
Все просто супер, я в восторге!
Обожаю этот сайт, он у меня в закладках!!!
не знаю что бы я мужу готовила если бы случайно не нашла этот сайт…
Мусс из куриной печенки с икрой из морса — очень вкусно!!!
потеряла рецепт.уже делала.
весь день искала и вот нашла!!!
УРААААА!!!
Спасибо очень вкусно, легко готовится, украсит любой праздник
Сегодня будем пробовать, просто в приготовлении, наверно и очень вкусно..
Мина, спасибо вам огромное за такой замечательный и легкий рецепт!!!
Вчера вычитала, а сегодня уже сделала.
Обалденный рецептик мусса из куриной печенки с икрой из морса. На удивление, даже у меня получилось приготовить его дома.
Самостоятельно!!!!!! :)
Блюдо на высшем уровне! Забираю в закладки. Спасибо за рецепт.
Обязательно сделаю, спасибо!
Старый добрый рецепт.
Сейчас буду готовить мусс из куриной печенки с икрой из морса по вашему рецепту.
уверена на 200% что будет вкусно:)
Мусс малиновый
Мусс
Мусс из лосося
Мусс